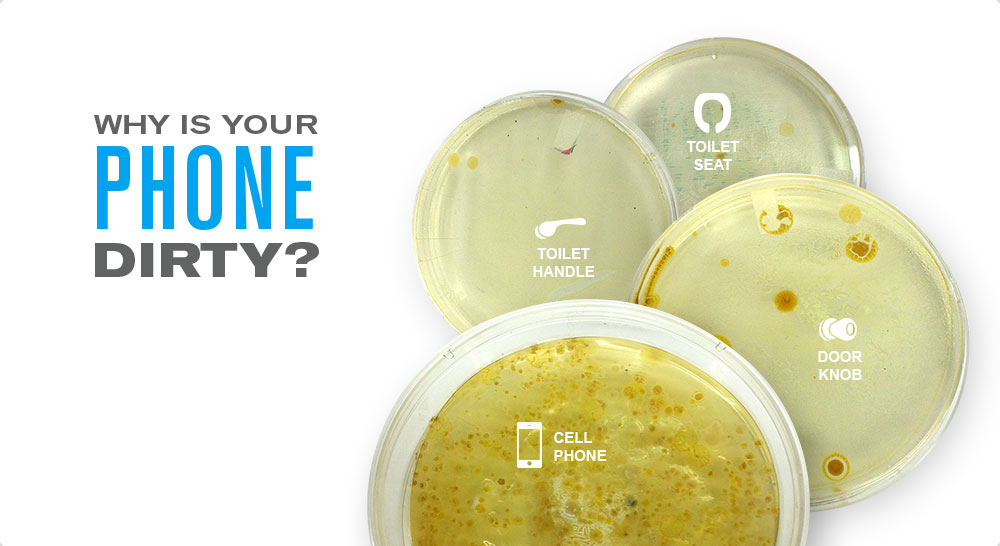
Les smartphones fourmillent d'applications santé, mais aussi de bactéries

LAS VEGAS, 10 janvier 2014 (AFP) - Le smartphone n'est pas forcément l'ami qu'on croit pour la santé, en dépit des applications mobiles promettant de l'améliorer qui pullulent au salon high-tech International CES à Las Vegas.
"Il est toujours chaud, rangé dans des endroits sombres, les bactéries se développent sur votre téléphone", prévient Dan Barnes, co-fondateur de la société américaine Phonesoap.
Cette dernière présente au CES une boîte de stérilisation, qui tue les bactéries du téléphone en même temps qu'elle le recharge.
"Tout a commencé au collège", raconte Dan Barnes à l'AFP. "Nous avons eu l'idée en lisant une étude selon laquelle les téléphones mobiles étaient 18 fois plus sales que des toilettes publiques".
La boîte de stérilisation de Phonesoap utilise les rayons UVC qui "détruit l'ADN des bactéries, de telle sorte qu'elles ne peuvent plus vivre sur votre téléphone", affirme Dan Barnes.
Le produit est vendu depuis novembre pour 49,95 dollars sur le site de la société, www.phonesoap.com, qui assure pouvoir l'expédier aux Etats-Unis comme à l'international. Une version plus grande, pour tablettes, est annoncée pour l'été.
L'idée semble faire des émules. Une autre société, CleanBeats, présente au CES un appareil sur lequel on pose l'appareil mobile pour le stériliser.
L'appareil revendique une technologie conçue par la Nasa, et intègre des enceintes pour lire la musique stockée sur le téléphone. Tout cela a quand même un prix: l'appareil sera bientôt sur le marché mais coûtera environ 499 dollars, selon son agent commercial, Dennis Rocha.
"Il est toujours chaud, rangé dans des endroits sombres, les bactéries se développent sur votre téléphone", prévient Dan Barnes, co-fondateur de la société américaine Phonesoap.
Cette dernière présente au CES une boîte de stérilisation, qui tue les bactéries du téléphone en même temps qu'elle le recharge.
"Tout a commencé au collège", raconte Dan Barnes à l'AFP. "Nous avons eu l'idée en lisant une étude selon laquelle les téléphones mobiles étaient 18 fois plus sales que des toilettes publiques".
La boîte de stérilisation de Phonesoap utilise les rayons UVC qui "détruit l'ADN des bactéries, de telle sorte qu'elles ne peuvent plus vivre sur votre téléphone", affirme Dan Barnes.
Le produit est vendu depuis novembre pour 49,95 dollars sur le site de la société, www.phonesoap.com, qui assure pouvoir l'expédier aux Etats-Unis comme à l'international. Une version plus grande, pour tablettes, est annoncée pour l'été.
L'idée semble faire des émules. Une autre société, CleanBeats, présente au CES un appareil sur lequel on pose l'appareil mobile pour le stériliser.
L'appareil revendique une technologie conçue par la Nasa, et intègre des enceintes pour lire la musique stockée sur le téléphone. Tout cela a quand même un prix: l'appareil sera bientôt sur le marché mais coûtera environ 499 dollars, selon son agent commercial, Dennis Rocha.